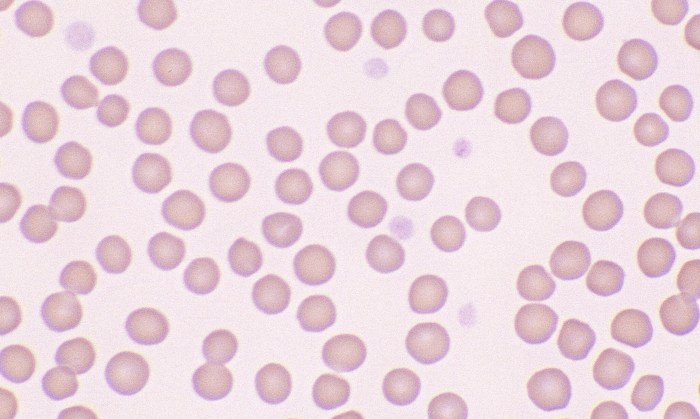
Normal Feline 1
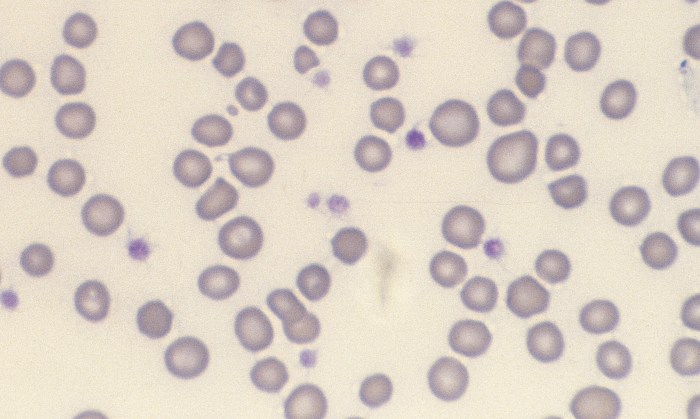
Normal Feline 2
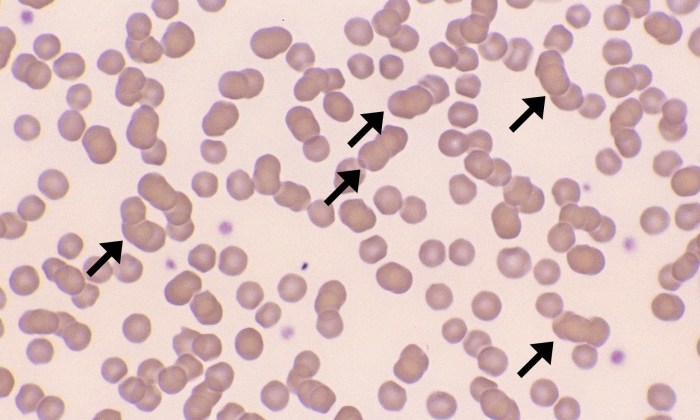
Normal Feline 3 (Rouleaux) ARROWS

Normal Feline Erythrocytes
Morphology: relatively small red blood cells with some variability in size and shape and little to no central pallor.
Lifespan: 65 – 76 days
Other features: rouleaux, occasional Howell-Jolly bodies, and small numbers of Heinz bodies may be present in healthy cats (feline hemoglobin is more susceptible to oxidant injury than other species). Polychromatophils are rare in healthy cats. Kittens (4-8 weeks of age) may show microcytosis due to physiologic iron deficiency.